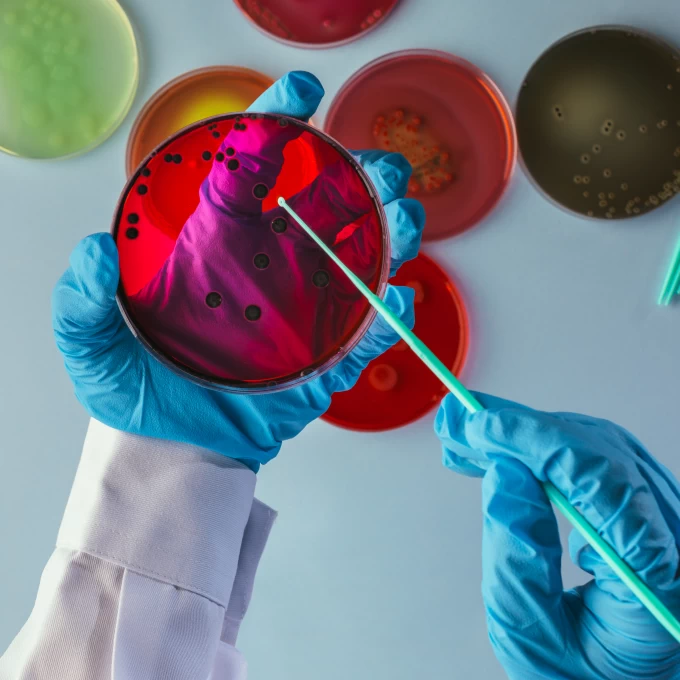

Une agence web agile et experte
Chez nous, pas de structures rigides, ni de production à la chaîne.
Nous travaillons en mode projet, avec une idée simple : chaque mission mérite une équipe adaptée. Nous constituons une équipe dédiée selon les besoins : designers, développeurs, vidéastes, rédacteurs, etc.
Nous intervenons sur l’ensemble du champ digital, avec une méthode de travail claire : collaboration, transparence, résultats.
Nous aimons le travail bien fait. Nous aimons que nos clients soient satisfaits, et que les leurs le soient aussi.
Parlons de votre projet, et voyons ce qu’il lui faut.
Audit & Conseil – Vous connaître, vous comprendre et vous accompagner
☛ Stratégie digitale, analyse technique, UX et SEO, recommandations, accompagnement à la rédaction de cahier des charges.
Création graphique – Une identité claire et durable
☛ Charte graphique, webdesign UX/UI, mobile-first, déclinaisons sur tous supports.
Création de site web – Des sites utiles, sobres, performants
☛ CMS WordPress ou sur-mesure, développement spécifique, intégration propre, animations, SEO, accessibilité, hébergement, maintenance.
Vidéo & Motion design – Vos message en images
☛ Motion design, interviews, teasers, formats courts, contenu pour les réseaux.
Focus
Références
Clients
Contact
Besoin d’infos ? D’un rendez-vous ? D’un devis ?